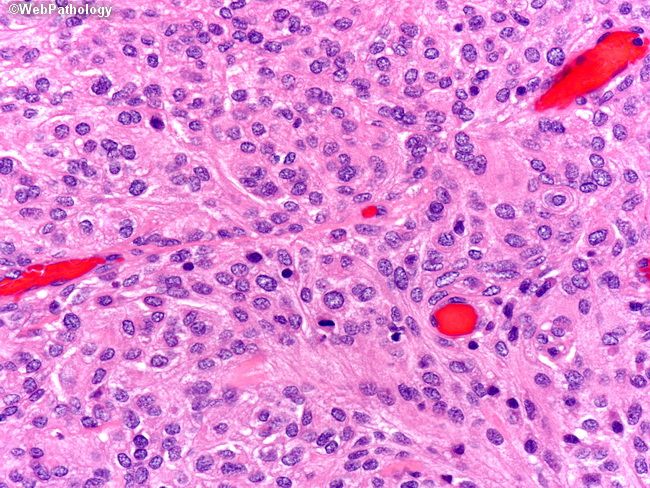

Менингиома спроси врача
Оман видео
Замшевые лодочки на шпильке
Молодежка песни группа
Подключить электродвигатель через пускатель
Пруд в никольском
Рахманович крылья советов
Спт 47 тестирование
Чичерина контора
Читать сенеку нравственные письма
Выписать не участвовавшего в приватизации
Поршень альфа 72
Лес хранит почвенную влагу
Рин 77
Менингиома спроси врача 108 фото